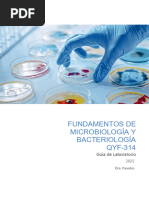

Tecnológico Nacional de México
Instituto Tecnológico de Ciudad Madero
Departamento de Ingeniería Química y Bioquímica
Microbiología 3575 A
Ingeniería Ambiental
Práctica 3.
Uso del Microscopio
Quinto Semestre
Estudiantes: Barragán Salas Michelle Ayerim 22071111
Medrano Balderas Ximena Guadalupe 22071381
Sifuentes Martínez Valeria Guadalupe 21071377
Docente: Lorena Margarita Salas Ordaz
Ciudad Madero Tam. Octubre 2024
� Guía de Observación y Lista de Cotejo para el trabajo de
laboratorio de Microbiología Ambiental y Toxicología Ambiental
Barragán Salas Michelle Ayerim
Nombre del alumno: Medrano Balderas Ximena Guadalupe
Sifuentes Martínez Valeria Guadalupe
Nombre del profesor: M.G.C. Lorena Margarita Salas Ordaz
Institución: Instituto Tecnológico de Ciudad Madero
Fecha de realización: 03 de octubre del 2024
Nombre de la práctica: Uso del Microscopio
Criterios de Evaluación
Aspecto a Observar Si No % Observaciones
Número y Nombre de la práctica
Objetivo
Introducción o Marco Teórico
Apartado de Seguridad
Procedimiento
Diagrama de flujo
Resultados y Observaciones
Conclusiones
Cuestionario
Bibliografía
2
� Trabajo en clase presencial (Laboratorio)
Aspecto a Observar Si No % Observaciones
Tuvo disponibilidad,
disciplina, trabajo de equipo
Llevó paso a paso el
desarrollo
Seguimiento del formato
establecido por el instructor
El resultado de la evaluación del contenido tiene un valor de 100 puntos.
El cumplimiento del alumno fue: ____________ puntos.
Para una calificación aprobatoria se requiere como mínimo 70 puntos.
3
�Objetivo
a) Conocer las partes y funcionamiento de un microscopio.
b) Tomar conocimiento del cuidado, manejo y utilidad de un microscopio en el
Laboratorio de Microbiología.
4
�Introducción
Casi la totalidad de los organismos unicelulares son imperceptibles para el ojo
humano, y para observarlos es esencial el microscopio. El uso de este dispositivo es
indispensable en el Laboratorio de Microbiología para el estudio de la morfología y
estructura de los microorganismos, así como su reacción a diferentes colorantes, lo
cual, junto con otros criterios, permitirá su identificación, por lo tanto, es importante
conocer su adecuado manejo.
Además de la ampliación de la imagen, en microscopía, hay que tener en cuenta dos
factores más: el contraste y la resolución. Los objetos deben poseer un cierto grado
de contraste con su medio circundante para poder ser percibidos a través del
microscopio. Por ello es por lo que la mayoría de los organismos necesitan ser
previamente teñidos para poder distinguirlos del medio (tinciones simples). Para
contrastar o realzar de forma específica distintas características morfológicas o
estructurales se emplean tinciones diferenciales. Estas técnicas tienen un gran
interés en la identificación y clasificación de las bacterias. La tinción diferencial más
utilizada es la tinción de Gram. Otras tinciones de gran importancia son las que
diferencian bacterias “ácido- alcohol resistentes”, las que diferencian estructuras
significativas como las esporas o la tinción negativa de cápsulas.
Por otra parte, el grado de resolución (la capacidad para ver separados dos objetos
adyacentes muy próximos entre sí), depende de las características del sistema de
lentes que posea el microscopio. Éste se encuentra limitado por la longitud de onda
de la luz emitida, el índice de refracción del medio en el que se realiza la visualización
y la apertura numérica del objetivo.
EL MICROSCOPIO
El microscopio compuesto (figura 2) es aquel que dispone de dos o más lentes de
aumento. Un microscopio se divide en dos partes: el soporte y el sistema óptico.
1. Soporte. Es la pieza fija en la que sólo la platina y el condensador tienen un
cierto movimiento. Sus principales partes son:
a. Base. Normalmente alberga la fuente de iluminación, en determinados
modelos
b. incorpora, además, un sistema porta filtros con varios filtros y un
diafragma de campo luminoso.
c. Brazo. Soporta todo el sistema óptico, el cabezal porta oculares y el
revólver porta objetivos. En él se dispone también un sistema de anclaje
de la platina (movimiento de enfocado de la preparación).
5
� d. Platina. Es la pieza donde se coloca la preparación microscópica para
su observación.
e. El Macrométrico y el Micrométrico. Ambos permiten enfocar la
preparación. El primero se emplea para un enfoque rápido cuando se
trabaja con objetivo de menor a de mayor aumento (x40, x100).
2. Sistema Óptico. Está formado por un cuerpo tubular donde se instalan las
lentes: los oculares en un extremo y los objetivos en el extremo opuesto.
6
�Materiales y reactivos
MATERIAL REACTIVOS
• 1 microscopio • Aceite de inmersión
• 3 portaobjetos • Solución de azul de metileno
• 1 cubreobjetos • Agua estancada (muestra)
• 1 asa de platino • Fibras de algodón (muestra)
• 1 mechero • Una tortilla o pan con hongo
• 1 piceta (muestra)
7
� Apartado de seguridad
Protección
Nomenclatura Riesgo Pictogramas Propiedades Físicas
Personal
Toxicidad oral: Puede
provocar náuseas,
vómitos y diarrea. Estado: físico o
líquido
Toxicidad por
inhalación: Puede irritar Color: amarillo
las vías respiratorias. claro
Peligro de aspiración: Olor: característico
Puede ser mortal si se
• Aceite de ingiere o penetra en las Inflamabilidad:
inmersión vías respiratorias. N/A este material es
Toxicidad acuática: Es combustible, pero
tóxico para los no fácilmente
organismos acuáticos. inflamable
Contaminación de Temperatura de
cursos de agua: Tanto autoinflamación:
el derrame como el agua 480 °C
de extinción pueden
contaminar los cursos de
agua.
Efectos en el medio
ambiente: Es nocivo Estado: físico
para los organismos sólido (polvo
acuáticos y puede cristalino)
provocar efectos
Color: verde
negativos a largo plazo oscuro
en el medio ambiente
acuático. Olor: inodoro
• Solución
de azul pH (valor): ~ 3
Reacciones alérgicas:
de metilo (agua: 10 g/l, 20
Puede provocar °C)
comezón, ronchas,
hinchazón en el rostro o Punto de
las manos, hinchazón o fusión/punto de
congelación: 180 -
hormigueo en la boca o
190 °C
garganta, opresión en el
pecho, y dificultad para
respirar.
8
�Efectos en el sistema
digestivo: Puede
causar molestias
digestivas, náuseas,
vómitos, y dolor
abdominal.
Efectos en el sistema
nervioso: Puede causar
cefalea, mareo, y
parestesia.
Efectos en el sistema
circulatorio: Dosis
excesivas pueden
causar
methemoglobinemia, y
dosis mayores de 15
mg/kg pueden causar
hemólisis.
9
�PROCEDIMIENTO
1. Observe el pan o tortilla, la fibra de algodón y el agua estancada a través del
objetivo de bajo poder. Es más fácil mantener las fibras de algodón en posición
fija para su observación si se coloca en medio una gota de agua sobre el
portaobjetos.
2. Repita las observaciones utilizando el objetivo de alto poder en seco, al
observar con este objetivo coloque un cubreobjetos sobre cada una de sus
preparaciones acuosas para proteger la lente del agua. Esto se le conoce como
montaje húmedo.
3. Finalmente observe un frotis bacteriano.
a. Poner una gota de agua sobre el portaobjetos. Esterilizar un asa de
platino calentándola a la llama de un mechero bunsen hasta que se
ponga de color rojo; dejarla enfriar.
b. Con el extremo del asa de platino, tocar una colonia bacteriana y
mezclarlas con el asa y con la gota de agua del portaobjetos. Extender
la gota lo más que se pueda sobre el portaobjetos. Secarlo calentándolo
sobre la llama del mechero. Cuando el portaobjetos este seco pasarlo
dos veces a través de la llama con el objeto de fijar el microscopio.
c. Teñir el microorganismo fijado en el portaobjetos. Esto consiste en
colocar el portaobjetos cobre el soporte para cubrirlo con la solución de
azul de metileno. Dejarlo así durante dos minutos. Lavar con agua y
secar el portaobjetos.
d. Observar los microorganismos al microscopio. Esto consiste en utilizar
el objetivo de inmersión con el cual se obtiene una mayor precisión. Para
ello se pone previamente una gota de aceite sobre la preparación a
observar (no se necesita cubreobjetos), bajando entonces el objetivo de
inmersión sobre el portaobjetos hasta que toque la gota de aceite.
10
�DIAGRAMA DE FLUJO
Cebolla
11
�RESULTADOS Y OBSERVACIONES
A continuación se dirán los resultados y las observaciones vistas de cada uno:
CEBOLLA
Resultados:
1. Estructura Celular: Se pueden ver células de cebolla que están
descomponiéndose. Las paredes celulares pueden aparecer dañadas o rotas.
2. Presencia de Hongos: Es posible notar hilos de micelio, que son parte de los
hongos, que pueden estar descomponiendo la cebolla. Estos hilos pueden tener un
aspecto filamentosos.
3. Bacterias: Se pueden observar agrupaciones de bacterias, las cuales pueden
estar contribuyendo a la descomposición de la materia orgánica.
4. Coloraciones: Las células pueden presentar coloraciones anormales debido a la
degradación y a la acción de microorganismos.
5. Líquidos e Intersticios: Puede haber acumulación de líquidos, que son productos
de la putrefacción y pueden llevar consigo microorganismos.
Observaciones:
• La descomposición es un proceso natural, y estos microorganismos son
esenciales para el reciclaje de nutrientes en el ecosistema.
• La célula de cebolla, al ser un tejido vegetal, muestra características diferentes
en comparación con células animales. Sin embargo, la descomposición afecta
ambas de manera similar.
• La temperatura y la humedad influyen en la velocidad de descomposición, lo
que puede ser evidente en el número de microorganismos observados.
CEBOLLA CAPA FINA
Resultados:
1. Células de Cebolla: Las células aparecerán como estructuras rectangulares y
organizadas en una capa, con paredes celulares bien definidas. El teñido resaltará
detalles de la morfología celular.
2. Coloración: Gracias al azul de metileno, las células se verán de un color azul
intenso. Este tinte tiñe especialmente los núcleos de las células, haciéndolos muy
visibles como estructuras ovaladas o redondeadas dentro de las células.
12
�3. Núcleo: Los núcleos estarán claramente definidos y se verán de un color más
oscuro que el citoplasma debido a la absorción del tinte. Este detalle es crucial para
la identificación de las células vegetales.
4. Citoplasma y Vacuolas: El citoplasma aparecerá más pálido en comparación con
el núcleo. Si hay vacuolas, también se pueden visualizar como espacios claros
dentro de las células.
5. Estructura de Pared Celular: Las paredes celulares serán visibles y aparecerán
como líneas delgadas que delimitan cada celda, lo que es característico de la
estructura celular de las plantas
Observaciones:
• Las células de cebolla son un excelente ejemplo para estudiar la estructura
celular debido a su simplicidad y claridad al ser observadas con un
microscopio.
• El uso de azul de metileno es útil para resaltar estructuras celulares,
particularmente núcleos y citoplasma, facilitando el estudio de la biología
celular.
• Esta técnica también permite entender la organización y el funcionamiento
básico de las células vegetales, lo cual es fundamental para estudios en
biología, botánica y microscopía.
FLOR MARCHITA
Resultados:
1. Estructura Celular: Las células del tallo pueden aparecer deformadas, con
paredes celulares que muestran signos de daño. Es posible ver espacios vacíos o
desintegración en las paredes.
2. Presencia de Moho: Se observarán filamentos de moho, que son parte del
micelio. Estos filamentos pueden tener un aspecto lanoso y variar en color (blanco,
verde, negro), dependiendo del tipo de hongo presente.
3. Bacterias: Alrededor del moho, se pueden ver pequeñas agrupaciones de
bacterias, que pueden estar contribuyendo a la descomposición del tallo.
4. Líquidos Exudados: Se observarán exudados o líquidos en el tejido del tallo, que
son productos de la descomposición y pueden tener una apariencia turbia.
5. Pérdida de Pigmentación: Las células del tallo pueden mostrar decoloración o
cambios en la pigmentación, reflejando daño celular y la acción de los hongos.
13
�Observaciones:
• El moho en el tallo de la flor indica un proceso de descomposición que puede
ser acelerado por condiciones ambientales como humedad y temperatura.
• La presencia de moho y bacterias enance la descomposición del tejido
vegetal, lo que juega un papel vital en el reciclaje de nutrientes en el
ecosistema.
• Si el tallo es parte de una flor aún con hojas, puede haber variación en el
estado de descomposición, ya que algunas partes pueden estar menos
afectadas que otras.
TOMATE
Resultados:
1. Descomposición Celular: Las células del tomate mostrarán signos evidentes de
descomposición, con paredes celulares dañadas y desintegradas.
2. Fungos y Moho: Se pueden observar filamentos de moho, como el género
Penicillium o Aspergillus. Estos hilos de micelio se extienden y pueden aparecer en
diferentes colores, desde blanco hasta verde o negro.
3. Bacterias: Agrupaciones de bacterias también serán visibles, algunas de las
cuales pueden estar involucradas en el proceso de descomposición. Pueden
aparecer como estructuras pequeñas y redondeadas.
4. Líquidos y Exudados: Habrá presencia de líquidos intercelulares, resultantes de
la ruptura celular y de la actividad de microorganismos, que pueden tener un aspecto
turbio.
5. Pérdida de Color: Las células del tomate pueden mostrar cambios de color,
evidenciando oxidación y degradación de pigmentos, a menudo perdiendo su brillo y
apariencia vibrante.
Observaciones:
• El proceso de descomposición es un fenómeno natural que permite la
transformación de materia orgánica en nutrientes disponibles para otros
organismos La abundancia de microorganismos en un tomate podrido es un
claro indicativo de la rapidez con que estos pueden colonizar y descomponer
materia orgánica.
• El entorno en el que se encuentra el tomate (humedad, temperatura) influye
significativamente en la velocidad de descomposición y en el tipo de
microorganismos presentes.
14
� Muestra EN EL MICROSCOPIO
Cebolla
Cebolla (capa fina)
Flor marchita
Tomate
15
�CONCLUSIONES
La práctica de microscopía tiene como objetivo principal introducir a los estudiantes
en el manejo y uso adecuado del microscopio, una herramienta indispensable en el
estudio de microorganismos que son invisibles a simple vista. El propósito es que los
participantes comprendan tanto las partes del microscopio como sus principios de
funcionamiento, además de familiarizarse con las técnicas de preparación de
muestras y su observación bajo diferentes niveles de aumento.
El microscopio óptico compuesto, utilizado en esta práctica, consta de un soporte y un
sistema óptico. Los estudiantes deben aprender a manejar con cuidado las lentes y
ajustar los objetivos según el tipo de muestra. El proceso de observación se realiza
en varios pasos, comenzando con el objetivo de menor aumento y pasando
gradualmente a mayores aumentos, llegando hasta el uso del objetivo de inmersión
(100x), donde se emplea aceite para mejorar la calidad de la imagen. Esto es crucial
para obtener una observación detallada de la morfología de los microorganismos.
Un aspecto clave de la práctica es la importancia de los factores de contraste y
resolución en la microscopía. Se resalta que, para mejorar la visibilidad de los
microorganismos, se aplican tinciones, como la de azul de metileno, que facilitan la
diferenciación de las estructuras celulares. Estas tinciones permiten identificar con
mayor precisión las características morfológicas, especialmente en bacterias, donde
es esencial observar su forma y disposición.
Durante el desarrollo experimental, los estudiantes analizan diversas muestras como
cebolla, tomate y flor marchita. Cada muestra se observa bajo diferentes objetivos,
comenzando por los de bajo poder, para luego pasar a mayores aumentos, utilizando
en algunos casos la técnica de montaje húmedo para preservar las características de
las muestras.
Finalmente, la práctica no sólo se centra en la observación de microorganismos, sino
que también fomenta la reflexión sobre conceptos fundamentales como el poder de
resolución, el aumento de la imagen y la iluminación adecuada. Se hace énfasis
en el mantenimiento y los cuidados que se deben tener al manipular un microscopio,
asegurando su buen estado para un uso prolongado y eficiente. Este enfoque integral
garantiza que los estudiantes no sólo adquieran habilidades técnicas, sino que
también desarrollen un conocimiento profundo sobre el papel crítico que juega la
microscopía en la microbiología y la biotecnología industrial.
16
�INVESTIGACIÓN
1. ¿A qué se llama poder de resolución? El poder de resolución es la capacidad
de un instrumento óptico, como un microscopio, para distinguir dos puntos separados
como entidades individuales. Se expresa generalmente en micrómetros y es crucial
para obtener imágenes claras y detalladas de los objetos observados.
2. ¿Cómo se determina el número de veces que se aumenta una imagen del
objeto que observamos? Explique cómo se puede tener una buena iluminación
en una observación. El aumento de un microscopio se determina multiplicando el
aumento del ocular por el aumento del objetivo. Por ejemplo, si un ocular tiene un
aumento de 10x y un objetivo de 40x, el aumento total es 400x. Para una buena
iluminación, se puede utilizar una luz intensa, ajustar el diafragma y mantener el
microscopio limpio para evitar sombras.
3. Resuma los cuidados fundamentales que se deben tener al manejar un
microscopio.
Los cuidados fundamentales incluyen:
• Mantener el microscopio limpio.
• No tocar las lentes con los dedos.
• Usar la perilla de enfoque con cuidado.
• No mover el microscopio bruscamente.
• Almacenar el microscopio cubierto cuando no esté en uso.
4. Explique el funcionamiento de los principales tipos de microscopios.
• Microscopio óptico: Utiliza luz visible y lentes para magnificar imágenes.
• Microscopio electrónico: Emplea electrones para crear imágenes de alta
resolución. Los tipos incluyen TEM (microscopio electrónico de transmisión) y
SEM (microscopio electrónico de barrido).
• Microscopio de fluorescencia: Utiliza luz fluorescente para observar
especímenes que emiten luz.
5. Señale las ventajas y desventajas de los principales tipos de microscopios
• Óptico: Ventajas: Fácil de usar, bajo costo. Desventajas: Limitado en poder de
resolución.
17
� • Electrónico: Ventajas: Alta resolución y aumento. Desventajas: Costoso y
requiere un entorno controlado.
• Fluorescencia: Ventajas: Permite observar estructuras específicas.
Desventajas: Puede ser complicado de usar y requiere marcadores
fluorescentes.
6. Qué función tiene el aceite de inmersión cuando se observa con el objetivo
de l00x? El aceite de inmersión reduce la refracción de la luz al pasar del vidrio al
aire, lo que permite una mejor transmisión de la luz y mejora la resolución al usar
objetivos de alto aumento.
7. Explique cómo se debe enfocar una preparación a menor y mayor aumento.
• Menor aumento: Colocar el objeto en el centro del campo visual, usar el
enfoque grueso hasta que la imagen sea clara.
• Mayor aumento: Cambiar al objetivo de alto aumento y usar el enfoque fino
para ajustar la claridad de la imagen sin mover la platina.
8. ¿Cuáles son las precauciones que se deben tener al usar el microscopio?
Las precauciones incluyen:
• Nunca tocar las lentes con los dedos.
• Evitar que los objetos se caigan de la platina.
• No usar fuerza excesiva al enfocar.
• Apagar la luz al terminar de usarlo.
9. ¿Cuál es el mantenimiento preventivo para el manejo adecuado del
microscopio?
El mantenimiento preventivo incluye:
• Limpieza regular de las lentes con papel especial.
• Revisar y ajustar la alineación óptica.
• Lubricar partes móviles según las recomendaciones del fabricante.
• Almacenar en un lugar seco y protegido.
18
�BIBLIOGRAFÍAS
1. [Link]
[Link]?context=bWFzdGVyfHNlY3VyaXR5RGF0YXNoZWV0c3wyODI3NDF8
YXBwbGljYXRpb24vcGRmfHNlY3VyaXR5RGF0YXNoZWV0cy9oNzYvaDMzL
zkwMjM5NjAwODg2MDYucGRmfDg0YTEwZGI5ZTA4ZTAxZDRhMGI4NzM2
NDVlMjNjZDFkNTUxODRlNjg1ZWE0MzQyYjFiYjI2ZWQ4YWRmMWMwYTM
2. [Link]
3. Atlas de Histología Vegetal y Animal; Depto. De Biología Funcional y Ciencias
de la Salud; Facultad de Biología; Universidad de Vigo
4. ALBERTS B., D. BRAY, J. LEWIS., M. RAFF, K. ROBERTS & J.D. WATSON.
Biología Molecular de la Célula. 5ª Ed. 2010.
5. COOPER, G.M. La Célula. 5ª edición. Marbán Libros, S.L., España. (2014).
6. CURTIS, H. Y N.S. BARNES. Biología. 7ª edición española. Editorial Médica
Panamericana. (2008).
7. Raven, P. H., & Johnson, G. B. (2014). Biology (10th ed.). McGraw-Hill.
8. Campbell, N. A., & Reece, J. B. (2017). Biology (11th ed.). Pearson.
9. Lombardi, M. (2011). Manual del microscopio: técnicas de uso y
mantenimiento. Ediciones Síntesis.
10. Heitz, M. P. (2012). Microscopía: fundamentos y técnicas. Editorial Médica
Panamericana.
11. Köhler, O. (2008). Microscopía moderna: principios y aplicaciones. Springer.
12. Rosenberg, J. (2015). Principios de microscopía óptica. Elsevier.
13. McCarthy, M. (2016). Guía práctica de microscopía. Ediciones Urano.
14. Baker, R. (2019). Uso seguro y mantenimiento del microscopio. Springer.
15. Smith, L. (2020). Mantenimiento de microscopios: Guía completa.
Wiley.
19